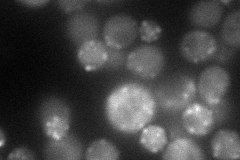
YNL020C
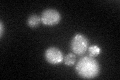
YNL020C
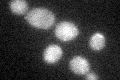
YNL020C

View description
Serine/threonine protein kinase involved in regulation of the cortical actin cytoskeleton; involved in control of endocytosis
Localization:
Intensity:
Fold change:
Significance:
-
C’ GFP library in SD

punctate22.26 -
N' NOP1pr-GFP in SD

punctate,bud58.7628 -
N' TEF2pr-mCherry in SD
punctate,bud neck58.1393 -
N' NATIVEpr-GFP in SD

punctate,bud neck28.2716 -
N' TEF2pr-VC and Cyto-VN in SD

punctate42.4758 -
C’ GFP library in SD+DTT
punctate29.731.33Yes -
C’ GFP library in SD+H2O2
punctate26.11.17No -
C’ GFP library in Starvation Media

punctate25.961.16No -
C’ GFP library on the background of Pup2-DaMP

punctate -
C’ GFP library on the background of CCT mutant

punctate22.34591.00336No
